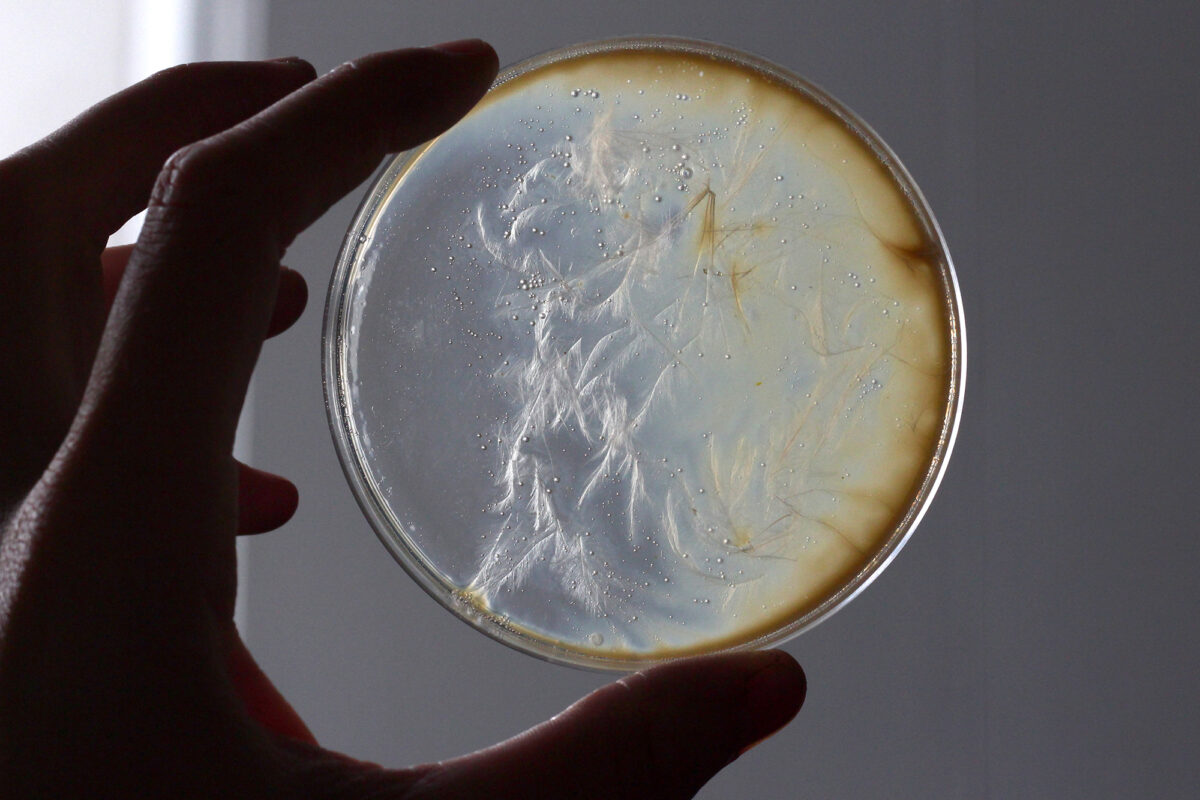

Savants mutants
Attention, attention, voici que débarquent des créatures drôlement affreuses ! Velu et plein d’écailles, avec un œil globuleux ou milles dents pointues, plein de griffes, de bosses et de cornes, le corps se déforme, et met le collage à l’honneur.
Du petit format à l’affiche, parler du monstre sera l’occasion de travailler sur son propre corps, allant jusqu’à réaliser un étrange masque. Et vous, quel genre de monstre incarnerez-vous ?